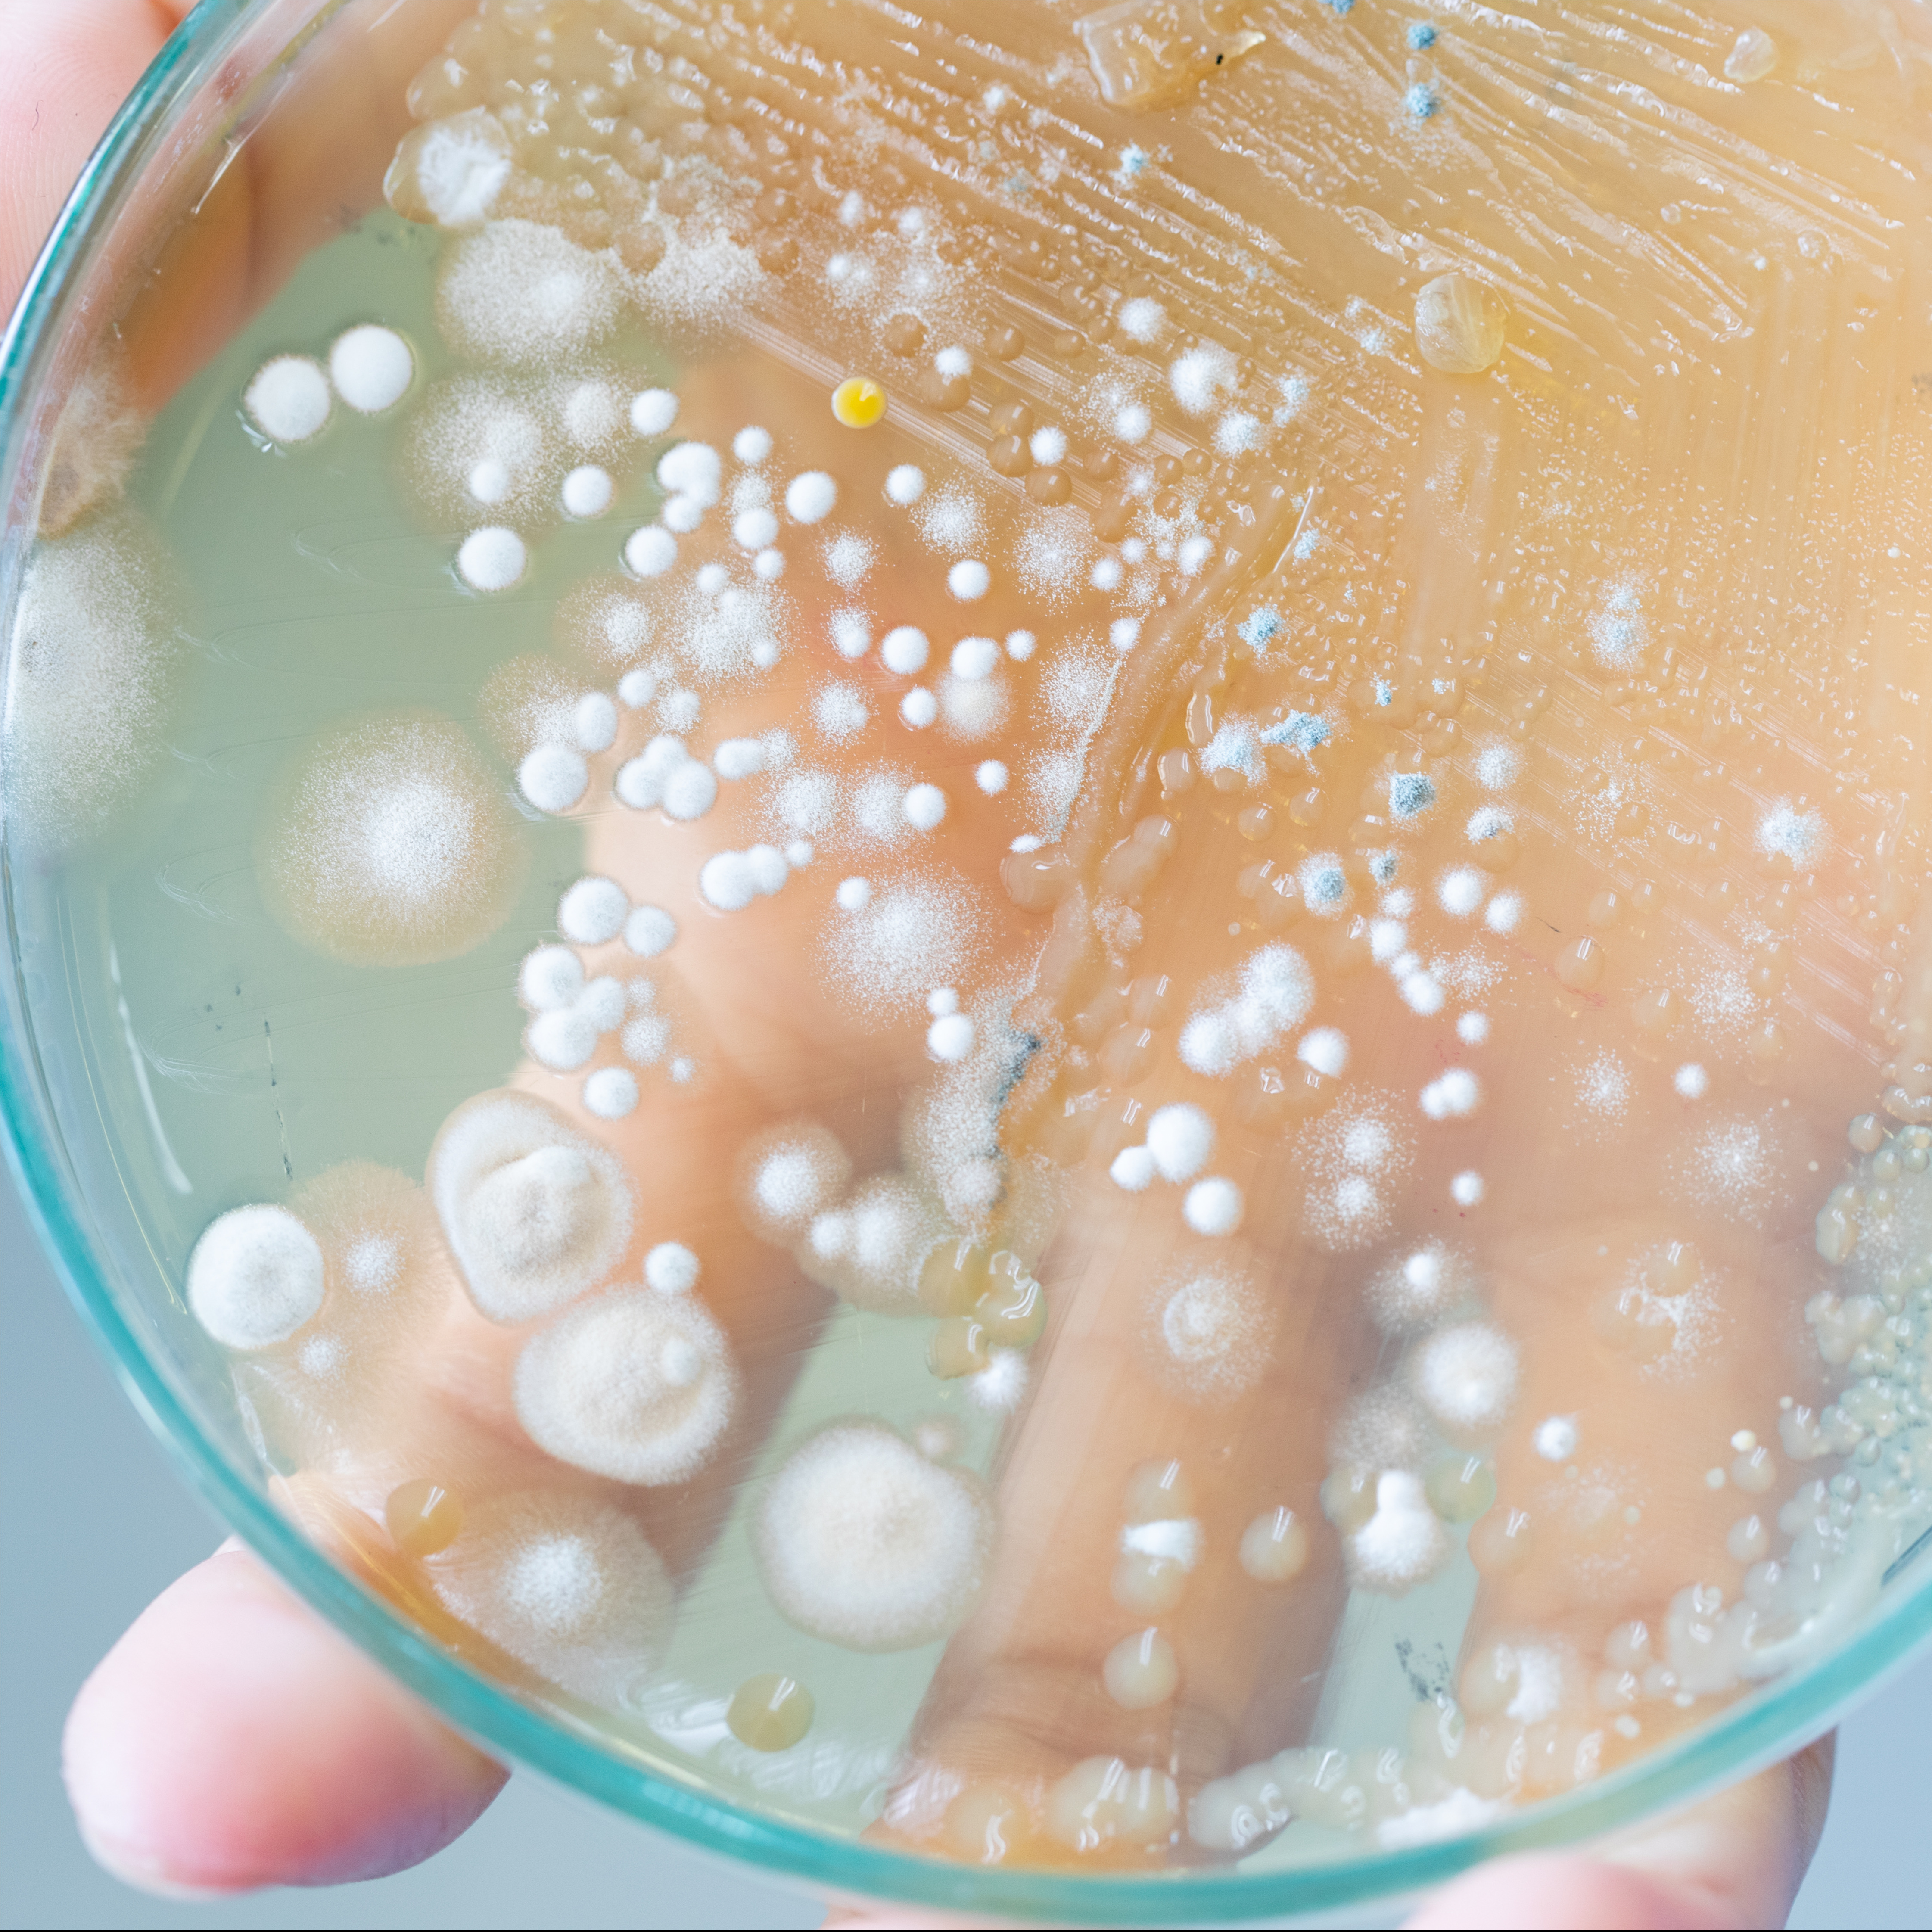
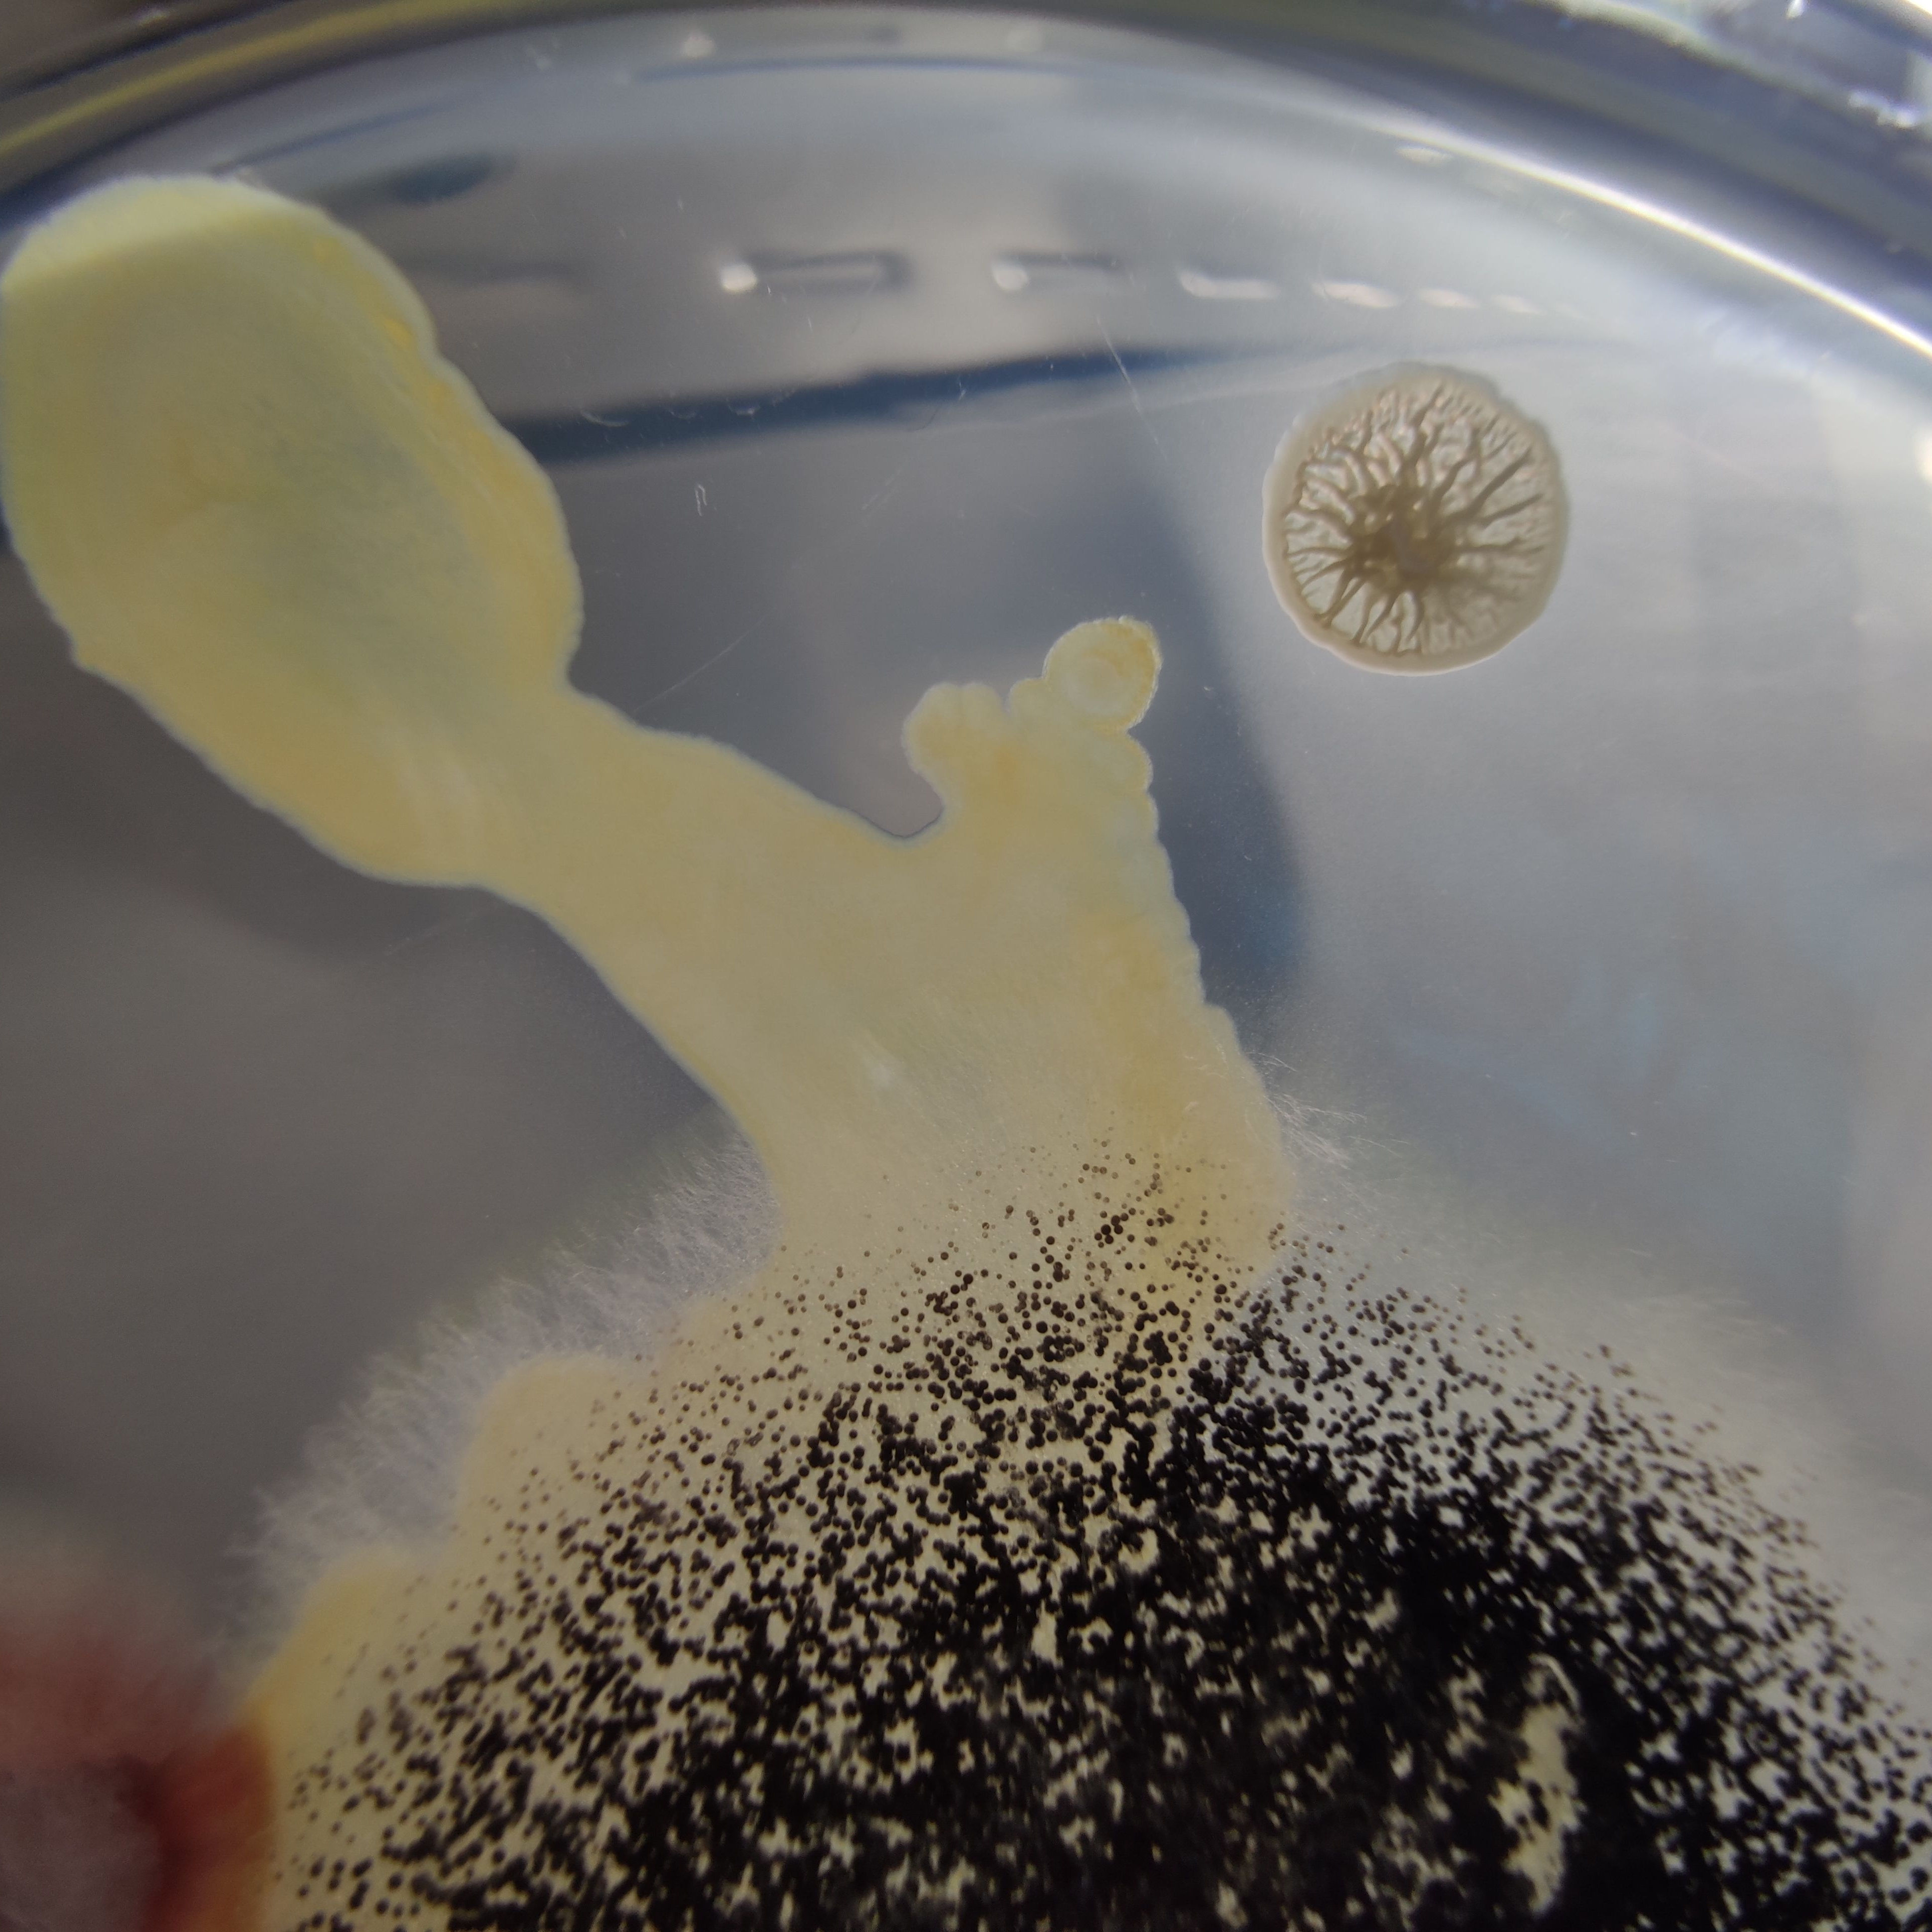

- Frekvenčné systémy
- Systémy NLS
-
Témy
- Nádory benígne (nezhubné)
- Nádor malígny (zhubný)
- Polypy
- Cysty
- Vírusy
- Baktérie
- Dermatológia a frekvencie
- Gynekológia a frekvencie
- Choroby a frekvencie
- Neoplázia a frekvenčná terapia
- Patogény a frekvenčná terapia
- Ezoterika a frekvenčná terapia
- Vodík - frekvenčná terapia
- Témy Elektrosmog
- Blog o bylinkách KE
- Základ frekvenčnej terapie
- Biozapper
- Hunter 4025 - Meta Hunter
- Frekvenčná terapia v Rakúsku
- Zdravie vo všeobecnosti
- Teória prvkov
- Mykoterapia
- Životne dôležité pole
- Alergie
- Rovnováha kyselín a zásad
- Hubové ochorenia
- Odporúčania kníh
- Doplnková medicína
- Doplnky
- E-Smog
- Frekvencie
- Analýza | Poradenstvo
- Vzdelávanie
Baktérie

Ureaplasma
von: Eder Herbert
29. mája 2024
Ureaplasma je rod baktérií, ktorý patrí do čeľade mykoplaziem a vyskytuje sa v ľudskej mikroflóre.

Actinobacillus equuli
von: Eder Herbert
13. januára 2024
Actinobacillus equuli je baktéria, ktorá sa vyskytuje najmä u koní a môže viesť k rôznym ochoreniam.
Actinomyzes clavatus
von: Eder Herbert
13. januára 2024
Pri liečbe infekcií spôsobených Actinomyces clavatus sa stretávame s komplexným organizmom, ktorý predstavuje výzvu pre pacientov aj lekárov.

Baktéria Acinetobacter a jej význam pre zdravie
von: Eder Herbert
13. januára 2024
Baktérie Acinetobacter patria do skupiny mikroorganizmov, ktoré sa nachádzajú v rôznych prostrediach vrátane pôdy, vody a tiež v zdravotníckych zariadeniach.

Endokarditída spojená s aktinobacilmi
von: Eder Herbert
10. januára 2024
Endokarditída spojená s aktinobacilmi: Skrytý nepriateľ vo vnútri srdca. Endokarditída je závažné ochorenie, ktoré postihuje vnútornú výstelku srdca, známu ako endokard.

Lactobacillus acidophilus
von: Eder Herbert
9. januára 2024
Lactobacillus acidophilus a úloha frekvenčnej terapie v manažmente mikrobiómu

Cancrum oris
von: Eder Herbert
20. apríla 2023
Cancrum oris sa nazýva aj noma alebo gangrenózny stomatit a označuje smrteľnú infekciu ústnej dutiny, ktorá postihuje ústa, nos a pery.

Darierova choroba
von: Eder Herbert
20. apríla 2023
Darierova choroba sa nazýva aj dyskeratóza folikulov a opisuje zriedkavé dedičné ochorenie kože spôsobené chromozomálnou mutáciou.

Mycoplasma genitalium
von: Eder Herbert
20. apríla 2023
Mycoplasma genitalium (genitálna mykoplazma) je baktéria, ktorá infikuje bunky sliznice urogenitálneho traktu.

Nano baktérie
von: Eder Herbert
20. apríla 2023
Nano baktérie boli objavené v bunkových kultúrach v roku 1994, nazývajú sa tiež ultra mikrobaktérie.

Streptokoky
von: Eder Herbert
20. apríla 2023
Streptokoky sú rozšíreným bakteriálnym druhom, ktorý má mnoho rôznych kmeňov.

Bacillus cereus
von: Eder Herbert
3. marca 2023
Bacillus cereus je pohyblivá, tyčinkovitá, gram- a kataláza-pozitívna, spórotvorná a fakultatívne anaeróbna baktéria patriaca do rodu Bacillus
Bacillus subtilis subsp. niger
von: Eder Herbert
3. marca 2023
Pojem Bacillus subtilis subsp. niger sa vzťahuje na patogén prenášaný vzduchom.

Bacteroides fragilis
von: Eder Herbert
3. marca 2023
Bacteroides fragilis patrí do rodu Bacteroides, nazývaného aj Bacteroidaceae.

Baktérie Bartonella
von: Eder Herbert
3. marca 2023
Bartonella je názov rodu baktérií. Väčšinou ide o parazitické baktérie, t. j. také, ktoré existujú v bunke hostiteľa (t. j. vnútrobunkové).

Bartonella alsatica
von: Eder Herbert
3. marca 2023
Bartonella alsatica je názov baktérie. Baktéria bola zistená v slezine a pečeni divých králikov a v pečeni domácich králikov.

Bartonella bacilliformis
von: Eder Herbert
3. marca 2023
Bartonella bacilliformis, známa aj ako juhoamerická bartonelóza, je tyčinkovitá baktéria patriaca do rodu Alphaproteobacteria.

Bartonella birtlesii
von: Eder Herbert
3. marca 2023
Bartonella birtlesii je fakultatívna intracelulárna baktéria. Konkrétne to znamená, že intracelulárne baktérie môžu vstupovať do cieľových buniek a množiť sa v cytoplazme.

Bartonella Bovis
von: Eder Herbert
3. marca 2023
Patogén Bartonella bovis, predtým známy aj ako Bartonella weissi, je patogénna baktéria. Baktéria bola prvýkrát izolovaná z európskych prežúvavcov (konkrétne z hovädzieho dobytka)

Bartonella clarridgeiae
von: Eder Herbert
3. marca 2023
Bartonella clarridgeiae patrí do rodu Bartonella a je to gramnegatívna baktéria. Patogén bol prvýkrát izolovaný v Spojených štátoch.

Bartonella Doshiae
von: Eder Herbert
3. marca 2023
Patogén Bartonella doshiae je baktéria a môže spôsobovať ochorenia zvierat. Postihuje najmä malé cicavce, ako sú potkany, ale aj myši, u ktorých bol zistený patogén Bartonella doshiae.

Bartonella Elizabethae
von: Eder Herbert
3. marca 2023
Patogény Bartonella elizabethae sú známe aj pod pôvodným názvom "Rochalimaea elizabethae". Ide o baktériu rodu Bartonella.

Bartonella grahamii
von: Eder Herbert
3. marca 2023
Patogén Bartonella grahamii je baktéria a patrí do rodu Bartonella

Bartonella koehlerae
von: Eder Herbert
3. marca 2023
Bartonella koehlerae sú baktérie rodu Bartonella. Sú opísané ako ľudský patogén, ktorý môže spôsobiť kultivačne negatívnu endokarditídu

Bartonella melophagi
von: Eder Herbert
3. marca 2023
Patogén Bartonella melophagi patrí medzi baktérie rodu Bartonella. Ide o gramnegatívne, vnútrobunkové baktérie, ktoré sa prenášajú vektormi.

Bartonella quintana
von: Eder Herbert
3. marca 2023
Patogén Bartonella quintana patrí do rodu Bartonella a je to gramnegatívna baktéria. Táto baktéria sa považuje za pôvodcu zákopovej horúčky a je rozšírená po celom svete

Bartonella rochalimae
von: Eder Herbert
3. marca 2023
Bartonella rochalimae patrí do rodu Bartonellaceae a je gramnegatívnym druhom baktérie

Bartonella schoenbuchensis
von: Eder Herbert
3. marca 2023
Bartonella schoenbuchensis pochádza z rodu Bartonella a je to baktéria. Patogén bol izolovaný z takzvaného semienka jeleňa (Lipoptena cervi)

Bartonella tamiae
von: Eder Herbert
3. marca 2023
Patogén Bartonella tamiae patrí do rodu Bartonella. Je to gramnegatívna tyčinkovitá baktéria, ktorá žije ako parazit vo vnútri hostiteľskej bunky

Bartonella taylorii
von: Eder Herbert
3. marca 2023
Bartonella taylorii patrí do rodu Bartonella a je to baktéria. Podobne ako iné druhy Bartonella, aj patogén Bartonella taylorii môže spôsobovať ochorenia u zvierat

Bartonella weisii
von: Eder Herbert
3. marca 2023
Patogén Bartonella weisii je dnes známejší ako Bartonella bovis. Je to patogénna baktéria, ktorá patrí do rodu Bartonella

Bordetella parapertussis
von: Eder Herbert
3. marca 2023
Bordetella parapertussis je baktéria z rodu Bordetella. Ide o malé gramnegatívne tyčinky, ktoré sú aeróbne, t. j. na svoje rozmnožovanie potrebujú kyslík

Campylobacter
von: Eder Herbert
3. marca 2023
Campylobacter sú baktérie, ktoré spôsobujú nákazlivé hnačkové ochorenia.

Citrobacter
von: Eder Herbert
3. marca 2023
Citrobacter spp. patrí do rodu gramnegatívnych anaeróbnych tyčinkových baktérií z čeľade Enterobacteriaceae.

Clostridium acetobutylicum
von: Eder Herbert
3. marca 2023
Clostridium acetobutylicum je grampozitívna baktéria patriaca do rodu Clostridia.

Lymfogranuloma venereum
von: Eder Herbert
3. marca 2023
Lymphogranuloma venereum je klasické pohlavné ochorenie a patrí k špeciálnej forme genitálnej chlamýdiovej infekcie

Pôvodcovia boreliózy Bartonella
von: Eder Herbert
3. marca 2023
Pôvodca bartonelovej boreliózy je baktéria, ktorú prenášajú kliešte.

Syncyciálny vírus
von: Eder Herbert
3. marca 2023
Respiračný syncyciálny vírus, nazývaný aj RS vírus alebo skrátene RSV, je vírus, ktorý vedie k splynutiu buniek v dýchacích cestách, t. j. v dýchacích cestách.

Bartonella tribocorum
von: Eder Herbert
2. marca 2023
Bartonella tribocorum je baktéria, ktorá patrí do rodu Bartonella. Podobne ako iné druhy Bartonella, aj B. tribocorum môže spôsobovať ochorenia u zvierat.

Clostridium botulinum
von: Eder Herbert
2. marca 2023
Clostridium botulinum je anaeróbny, t. j. bez kyslíka rastúci zárodok, ktorý tvorí spóry, a preto má dlhú dobu prežitia